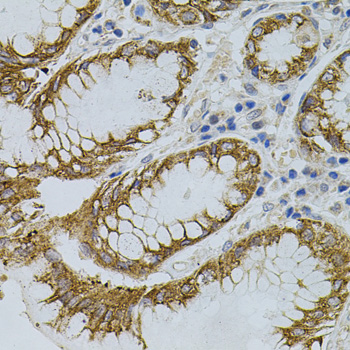
Immunohistochemistry - SIGMAR1 Polyclonal Antibody

-
Product Name
SIGMAR1 Polyclonal Antibody
- Documents
-
Description
Polyclonal antibody to SIGMAR1
-
Tested applications
WB, IHC
-
Species reactivity
Human, Mouse, Rat
-
Alternative names
SIGMAR1 antibody; ALS16 antibody; DSMA2 antibody; OPRS1 antibody; SIG-1R antibody; SR-BP antibody; SR-BP1 antibody; SRBP antibody; hSigmaR1 antibody; sigma1R antibody; sigma non-opioid intracellular receptor 1 antibody
-
Isotype
Rabbit IgG
-
Preparation
Antigen: Recombinant protein of human SIGMAR1
-
Clonality
Polyclonal
-
Formulation
PBS with 0.02% sodium azide, 50% glycerol, pH7.3.
-
Storage instructions
Store at -20℃. Avoid freeze / thaw cycles.
-
Applications
WB 1:500 - 1:2000
IHC 1:100 - 1:200 -
Validations

Western blot - SIGMAR1 Polyclonal Antibody
Western blot analysis of extracts of various cell lines, using SIGMAR1 antibody at 1:500 dilution.Secondary antibody: HRP Goat Anti-Rabbit IgG (H+L) at 1:10000 dilution.Lysates/proteins: 25ug per lane.Blocking buffer: 3% nonfat dry milk in TBST.Detection: ECL Basic Kit .Exposure time: 90s.
Immunohistochemistry - SIGMAR1 Polyclonal Antibody
Immunohistochemistry of paraffin-embedded human stomach using SIGMAR1 antibody (40x lens).

Immunohistochemistry - SIGMAR1 Polyclonal Antibody
Immunohistochemistry of paraffin-embedded mouse brain using SIGMAR1 antibody (40x lens).

Immunohistochemistry - SIGMAR1 Polyclonal Antibody
Immunohistochemistry of paraffin-embedded mouse kidney using SIGMAR1 antibody (40x lens).
-
Background
Functions in lipid transport from the endoplasmic reticulum and is involved in a wide array of cellular functions probably through regulation of the biogenesis of lipid microdomains at the plasma membrane. Involved in the regulation of different receptors it plays a role in BDNF signaling and EGF signaling. Also regulates ion channels like the potassium channel and could modulate neurotransmitter release. Plays a role in calcium signaling through modulation together with ANK2 of the ITP3R-dependent calcium efflux at the endoplasmic reticulum. Plays a role in several other cell functions including proliferation, survival and death. Originally identified for its ability to bind various psychoactive drugs it is involved in learning processes, memory and mood alteration. Necessary for proper mitochondrial axonal transport in motor neurons, in particular the retrograde movement of mitochondria. Plays a role in protecting cells against oxidative stress-induced cell death via its interaction with RNF112 (By similarity).
Related Products / Services
Please note: All products are "FOR RESEARCH USE ONLY AND ARE NOT INTENDED FOR DIAGNOSTIC OR THERAPEUTIC USE"
